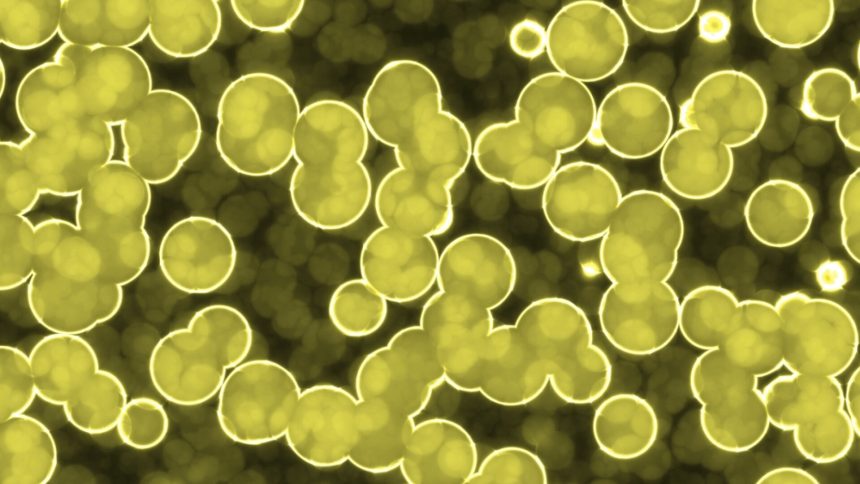

Revoluție în Spațiu: Bacteriile care Supraviețuiesc lansării în Cosmos!
O descoperire uluitoare din Australia promite să schimbe viitorul misiunilor spațiale! O rachetă testată recent a demonstrat că anumite bacterii esențiale pentru sănătatea umană pot supraviețui călătoriei în spațiu și revenirii pe Pământ. Aceste descoperiri oferă speranțe enorme pentru misiunile către Marte!
Provocările Misiunilor pe Marte
Agențiile spațiale se pregătesc să trimită echipaje de astronauți pe Marte în următoarele decenii, dar menținerea vieții pe „Planeta Roșie” ar putea fi mult mai complicată fără anumite bacterii vitale. Oamenii de știință au realizat un experiment fascinant, trimițând spori de Bacillus subtilis – un microb care susține imunitatea și sănătatea intestinală – la marginea atmosferei terestre.
Testul Extrem: 13 G și 30 G
Acest experiment a avut loc la bordul unei rachete lansate din Suedia, iar încărcătura a experimentat o accelerație incredibilă de până la 13 G, timp de mai mult de șase minute în microgravitație. La reintrarea în atmosferă, sporii au fost supuși unor forțe de 30 G, în timp ce racheta se rotea cu o viteză de 220 de ori pe secundă!
Rezultate Promițătoare
După recuperare, sporii de Bacillus subtilis nu au prezentat nicio modificare în capacitatea lor de a crește, dovedind că acest microb esențial poate supraviețui călătoriei în spațiu. Aceasta deschide calea pentru dezvoltarea unor sisteme mai eficiente de susținere a vieții pentru astronauți, asigurându-le sănătatea în timpul misiunilor îndelungate.
Implicații pentru Viitor
Studiul efectuat în colaborare cu ResearchSat și Numedico Technologies nu doar că îmbunătățește înțelegerea noastră asupra vieții în condiții extreme, dar are și aplicații potențiale în biotehnologie și în lupta împotriva bacteriilor rezistente la antibiotice. Această cercetare ar putea transforma radical modul în care ne gândim la explorarea spațială! Viitorul misiunilor către Marte ar putea fi mai luminos decât ne imaginăm, datorită acestor bacterii neînfricate!